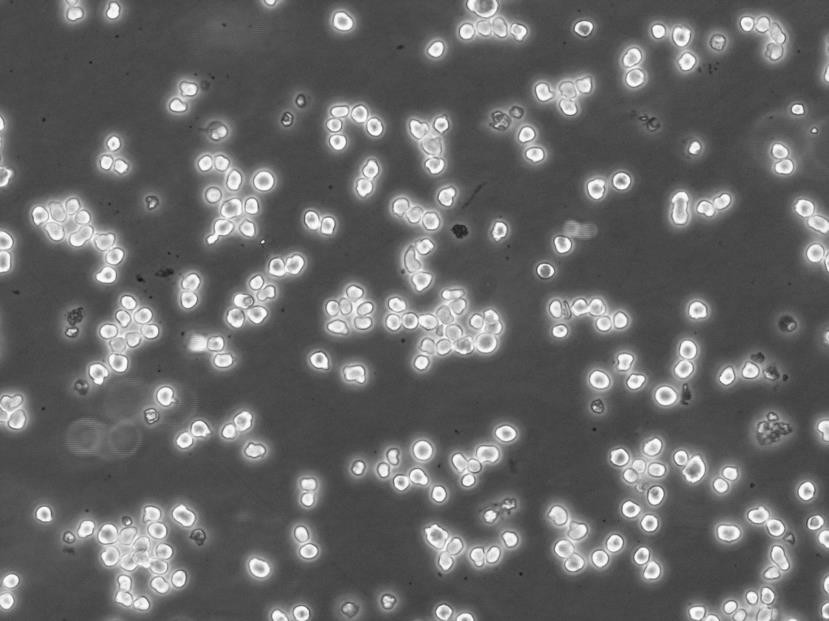
J774A.1 Cells:小鼠单核巨噬细胞系代次低(带STR鉴定报告)

"J774A.1 Cells:小鼠单核巨噬细胞系代次低(带STR鉴定报告)
换液周期:每周2-3次
传代比例:1:2-1:4(首次传代建议1:2)
背景信息:详见相关文献介绍
┈订┈购(技术服务)┈热┈线:1┈3┈6┈4┈1┈9┈3┈0┈7┈9┈1【微信同号】┈Q┈Q:3┈1┈8┈0┈8┈0┈7┈3┈2┈4;
DSMZ菌株保藏中心成立于1969年,是德国的国家菌种保藏中心。该中心一直致力于细菌、真菌、质粒、抗菌素、人体和动物细胞、植物病毒等的分类、鉴定和保藏工作。DSMZ菌种保藏中心是欧洲规模最大的生物资源中心,保藏有动物细胞500多株。Riken BRC成立于1920年,是英国的国家菌种保藏中心。该中心一直致力于细菌、真菌、植物病毒等的分类、鉴定和保藏工作。日本Riken BRC(Riken生物资源保藏中心)是全球三大典型培养物收集中心之一。Riken保藏中心提供了很多细胞系。在世界范围内,这些细胞系,都在医学、科学和兽医中具有重要意义。Riken生物资源中心支持了各种学术、健康、食品和兽医机构的研究工作,并在世界各地不同组织的微生物实验室和研究机构中使用。
CEL Cells;背景说明:胚胎;肝 Cells;传代方法:1:2-1:3传代;每周换液2-3次。;生长特性:贴壁;形态特性:详见产品说明书;相关产品有:FCCH1024细胞、U266S细胞、H-2342细胞
MB231 Cells;背景说明:MDA-MB-231来自患有转移乳腺腺癌的51岁女病人的胸水。在裸鼠和ALS处理的BALB/c小鼠中,它能形成低分化腺癌(III级)。;传代方法:消化3-5分钟,1:2,3天内可长满;生长特性:贴壁生长;形态特性:上皮样;相关产品有:MKN 45细胞、KNS-81细胞、NRK 49F细胞
NCI-H2029 Cells;背景说明:详见相关文献介绍;传代方法:1:3-1:5传代;;生长特性:贴壁生长;形态特性:详见产品说明书;相关产品有:Ku812细胞、P30 OHK细胞、SK-NEP-1细胞
Tn5 B1-4 Cells;背景说明:详见相关文献介绍;传代方法:1:2-1:3传代;每周换液2-3次。;生长特性:贴壁或悬浮,详见产品说明书部分;形态特性:详见产品说明书;相关产品有:CORL51细胞、UCLA-RO 81细胞、B-3细胞
J774A.1 Cells:小鼠单核巨噬细胞系代次低(带STR鉴定报告)
生长特性:悬浮生长
产品包装:复苏发货:T25培养瓶(一瓶)或冻存发货:1ml冻存管(两支)
细胞培养过程中相关问题总结:悬浮性细胞应如何继代处理?一般仅需持续加入新鲜培养基于原培养角瓶中,稀释细胞浓度即可,若培养太多时,可将培养角瓶口端稍微抬GAO,直到无法容纳为止。分瓶时取出一部份含细胞之培养至另一新的培养角瓶,加入新鲜培养基稀释至适当浓度,重复前述步骤即可。欲将一般动物细胞离心下来,其离心速率应为多少转速?欲回收动物细胞,其离心速率一般为300xg(约1,000rpm),5-10分钟,过GAO之转速,将造成细胞死亡;细胞之接种密度为何?依照细胞株基本数据上之接种密度或稀释分盘之比例接种即可。细胞数太少或稀释的太多亦是造成细胞无法生长之一重要原因;细胞冷冻培养基之成份为何?动物细胞冷冻保存时Zui常使用的冷冻培养基是含5-10%DMSO(dimehyl sulfoxide)和90-95%原来细胞生长用之新鲜培养基均匀混合之。注意:由于DMSO稀释时会放出大量热能,故不可将DMSO直接加入细胞中,必须使用前先行配制完成;DMSO之等级和无菌过滤之方式为何?冷冻保存使用之DMSO等级,必须为issue culure grade之DMSO,其本身即为无菌状况,第一次开瓶后应立即少量分装于无菌试管中,保存于4°C,避免反复冷冻解冻造成DMSO之裂解而释出有害物质,并可减少污染之机会。若要过滤DMSO,则须使用耐DMSO之Nylon材质滤膜;冷冻保存细胞之方法?冷冻保存方法一:冷冻管置于4°C 30~60分钟→ (-20°C 30分钟)→-80°C 16~18小时(或隔夜)→槽vaporphase长期储存。冷冻保存方法二:冷冻管置于已设定程序之可程序降温机中每分钟降1-3°C至–80°C以下,再放入槽vapor phase长期储存。-20°C不可超过1小时,以防止冰晶过大,造成细胞大量死亡,亦可跳过此步骤直接放入-80°C冰箱中,惟存活率稍微降低一些;细胞欲冷冻保存时,细胞冷冻管内应有多少细胞浓度?冷冻管内细胞数目一般为1x10(6)/ml vial,融合瘤细胞则以5x10(6)/ml vial为宜;应如何避免细胞污染?细胞污染的种类可分成细菌、酵母菌、霉菌、病毒和霉浆菌。主要的污染原因为无菌操作技术不当、操作室环境不佳、污染之血清和污染之细胞等。严格之无菌操作技术、清洁的环境、与品质良HAO之细胞来源和培养基配制是减低污染之ZuiHAO方法;如果细胞发生微生物污染时,应如何处理?直接灭菌后丢弃之。
来源说明:细胞主要来源ATCC、ECACC、DSMZ、RIKEN等细胞库
┈订┈购(技术服务)┈热┈线:1┈3┈6┈4┈1┈9┈3┈0┈7┈9┈1【微信同号】┈Q┈Q:3┈1┈8┈0┈8┈0┈7┈3┈2┈4;
J774A.1 Cells:小鼠单核巨噬细胞系代次低(带STR鉴定报告)
物种来源:人源、鼠源等其它物种来源
NCI.H460 Cells;背景说明:该细胞1982年由A.F.Gazdar建系,源自一位患有大细胞肺癌的男性的胸腔积液。该细胞角蛋白、波形蛋白阳性。;传代方法:1:2传代;生长特性:贴壁生长;形态特性:上皮样;相关产品有:THP-1(ATCC)细胞、P3J HR-1细胞、NS-I/1细胞
Leghorn Male Hepatoma cell line Cells;背景说明:肝癌;雄性;传代方法:1:2-1:3传代;每周换液2-3次。;生长特性:贴壁;形态特性:详见产品说明书;相关产品有:2V6.11细胞、P-19细胞、COR-L 105细胞
NUGC-2 Cells;背景说明:详见相关文献介绍;传代方法:1:2-1:3传代;每周换液2-3次。;生长特性:贴壁或悬浮,详见产品说明书部分;形态特性:详见产品说明书;相关产品有:LNCaP C4-2细胞、HBE 135-E6/E7细胞、H1703细胞
HTh-74 Cells;背景说明:未分化甲状腺癌;女性;传代方法:1:2-1:3传代;每周换液2-3次。;生长特性:贴壁;形态特性:详见产品说明书;相关产品有:Mel-MeWo细胞、HSC-I细胞、YD-15细胞
GM20015 Cells(提供STR鉴定图谱)
形态特性:巨噬细胞样
公司细胞库冻存并保种有2300多种各类细胞系。针对每种不同的细胞系,公司摸索并积累了大量细胞培养条件和YOU化参数,为您的细胞实验保驾护航。细胞培养是生命科学研究中Zui基础、也是Zui常用的实验手段。从冻存→复苏→传代→实验,在每一次细胞培养的过程中我们都是精心呵护,小心培养,心里都是默默承诺:我要护你一世周全!可是可是……无数次细胞都因污染而离我而去,投入的不只是我们貌美如花的青春,还有那一去不复返的经费!在细胞生物学,生物化学,免疫学,神经生物学,病理学……只要涉及细胞的研究领域,都面临着支原体污染的威胁。在众多污染物中,也就属支原体Zui狡猾了,他Zui善于隐藏自己,因为被支原体污染的细胞不会马上死亡,但会改变细胞的新陈代谢,甚至会改变细胞的基因表达谱,我们就这样被欺骗了无数次,谁让我们就是个看“颜值”的花痴了。可是我们通过被虐了几百次的经验中总结出来,当你的细胞出现了这些症状时:生长速率改变;活性减弱;形态改变;染色体畸变;转染效率显著降低;细胞复苏后存活率降低……。那你就得千万小心了,也许你的细胞已经被支原体欺凌了!
A375 XPA-mutated clone A9 Cells(提供STR鉴定图谱)
Abcam PC-3 CCRL2 KO Cells(提供STR鉴定图谱)
B1C3 Cells(提供STR鉴定图谱)
BayGenomics ES cell line RRQ119 Cells(提供STR鉴定图谱)
BayGenomics ES cell line YHC357 Cells(提供STR鉴定图谱)
CENSOi020-A Cells(提供STR鉴定图谱)
DA01354 Cells(提供STR鉴定图谱)
DD1709 Cells(提供STR鉴定图谱)
GM01998 Cells(提供STR鉴定图谱)
MDA-361 Cells;背景说明:该细胞源自40岁女性乳腺癌的脑转移组织。;传代方法: 1:2—1:6传代,每周换液2—3次;生长特性:松散贴壁生长;形态特性:上皮细胞样;相关产品有:MCF7-CTRL细胞、C-28/I2细胞、MFE-280细胞
NCI-H441-4 Cells;背景说明:NCI-H441建系于1982年(A.F.Gazdar,etal.)。该细胞分离自一名肺腺癌患者的心包液。该细胞能在半固体琼脂糖中形成克隆,并能表达肺泡表面活性蛋白A。该细胞在有血清培养基中倍增时间为58小时,在无血清培养基中倍增时间为99-138小时。;传代方法:1:3传代,2-3天传一代;生长特性:贴壁生长;形态特性:上皮细胞样;相关产品有:H1975细胞、BNL.1ME A.7R.1细胞、Human Corneal Endothelial Cells-12细胞
NB19-RIKEN Cells;背景说明:神经母细胞瘤;女性;传代方法:1:2-1:3传代;每周换液2-3次。;生长特性:贴壁;形态特性:详见产品说明书;相关产品有:MODE-K细胞、NCI-H2342细胞、IPEC-J2细胞
RPTEC TERT1 Cells;背景说明:肾;近端小管上皮;HGNC-TERT转化;男性;传代方法:1:2-1:3传代;每周换液2-3次。;生长特性:贴壁;形态特性:详见产品说明书;相关产品有:786O细胞、H2591细胞、CF PAC-1细胞
H2085 Cells;背景说明:详见相关文献介绍;传代方法:1:3-1:6传代 ;生长特性:贴壁生长;形态特性:上皮细胞;相关产品有:Epstein-Barr-1细胞、MC3T3, E1 subgroup-4 clone细胞、H1618细胞
NCI660 Cells;背景说明:详见相关文献介绍;传代方法:2-3天换液1次。;生长特性:悬浮生长;形态特性:上皮细胞;相关产品有:87 MG细胞、NCI-H23细胞、MV 4;11细胞
U-87MG Cells;背景说明:详见相关文献介绍;传代方法:1:2-1:3传代;每周换液2-3次。;生长特性:贴壁或悬浮,详见产品说明书部分;形态特性:详见产品说明书;相关产品有:D341Med细胞、B16/BL6细胞、TT细胞
HEK-293-EBNA Cells;背景说明:详见相关文献介绍;传代方法:1:4-1:10传代;每周2次。;生长特性:贴壁生长;形态特性:上皮细胞样;相关产品有:32Dcl3细胞、Bac 1.2F5细胞、BALB/3T3 clone A31细胞
ND7/23 Cells;背景说明:神经母细胞瘤;传代方法:1:2-1:3传代;每周换液2-3次。;生长特性:贴壁;形态特性:详见产品说明书;相关产品有:BA/F3细胞、LN229细胞、P3X63 Ag8细胞
J774A.1 Cells:小鼠单核巨噬细胞系代次低(带STR鉴定报告)
RERF-LC-MS Cells;背景说明:详见相关文献介绍;传代方法:每周换液2次。;生长特性:贴壁生长;形态特性:上皮细胞样;相关产品有:NH6细胞、H-211细胞、RBL-I细胞
A72 Cells;背景说明:癌细胞;金毛猎犬;传代方法:1:2-1:3传代;每周换液2-3次。;生长特性:贴壁;形态特性:详见产品说明书;相关产品有:JROECL19细胞、P3/NS1/1-Ag4.1细胞、PF382细胞
OVCAR-10 Cells;背景说明:卵巢癌;女性;传代方法:1:2-1:3传代;每周换液2-3次。;生长特性:贴壁;形态特性:详见产品说明书;相关产品有:IAR20细胞、NK-92MI细胞、Hs 895.T细胞
PIG3 Cells;背景说明:皮肤;黑色素 Cells;传代方法:1:2-1:3传代;每周换液2-3次。;生长特性:贴壁;形态特性:详见产品说明书;相关产品有:HT 29细胞、786-O RCC细胞、JURKAT E-61细胞
┈订┈购(技术服务)┈热┈线:1┈3┈6┈4┈1┈9┈3┈0┈7┈9┈1【微信同号】┈Q┈Q:3┈1┈8┈0┈8┈0┈7┈3┈2┈4;
Colon38 Cells;背景说明:详见相关文献介绍;传代方法:1:2传代;生长特性:贴壁生长;形态特性:上皮细胞样;相关产品有:H125细胞、RC13细胞、JF305细胞
AgC11x3A Cells;背景说明:NR8383(正常大鼠,1983年8月3日)来源于肺灌洗时的正常大鼠肺泡巨噬细胞。细胞在gerbil肺细胞连续培养液存在下培养了大约8-9个月。随后,不再需要外源生长因子。通过有限稀释法从单个细胞克隆并亚克隆NR8383细胞,并三次用软琼脂亚克隆。细胞表现出巨噬细胞的特性,吞噬酵母多糖和铜绿,非特异性脂酶活性,Fc受体,氧化降解;分泌IL-1,TNFbeta和IL-6,可重复地响应外源生长因子。NR8383细胞响应博莱霉素,分泌TGFbeta前体。在博莱霉素刺激下,TGFbe;传代方法:1:2传代;生长特性:半贴壁生长;形态特性:巨噬细胞;相关产品有:Cloudman M3细胞、SUM 102细胞、NTera 2/cl.D1细胞
SK-UT-1 Cells;背景说明:详见相关文献介绍;传代方法:1:4-1:12传代,2天换液1次。;生长特性:贴壁生长;形态特性:上皮细胞;相关产品有:TE-14细胞、3-LL细胞、HPAEpiC细胞
SK-UT-1 Cells;背景说明:详见相关文献介绍;传代方法:1:4-1:12传代,2天换液1次。;生长特性:贴壁生长;形态特性:上皮细胞;相关产品有:TE-14细胞、3-LL细胞、HPAEpiC细胞
SL-29 Cells;背景说明:胚成纤维细胞; White Leghorn SPAFAS;传代方法:1:2-1:3传代;每周换液2-3次。;生长特性:贴壁;形态特性:详见产品说明书;相关产品有:MB39细胞、LED-WiDr细胞、E0771细胞
Colo-678 Cells;背景说明:详见相关文献介绍;传代方法:1:2-1:3传代;每周换液2-3次。;生长特性:贴壁或悬浮,详见产品说明书部分;形态特性:详见产品说明书;相关产品有:SupB15WT细胞、Hela-mock细胞、Biopsy xenograft of Pancreatic Carcinoma line-3细胞
ONS76 Cells;背景说明:详见相关文献介绍;传代方法:1:2传代;生长特性:贴壁生长;形态特性:上皮样;相关产品有:TCam 2细胞、He-La细胞、MG63细胞
HCC1954 BL Cells;背景说明:外周血B淋巴细胞;EBV转化;女性;传代方法:1:2-1:3传代;每周换液2-3次。;生长特性:悬浮;形态特性:详见产品说明书;相关产品有:Sun Yat-sen university Ophtalmic center-Retinoblastoma 50细胞、HPC-Y5细胞、SW 900细胞
EBNA293 Cells;背景说明:详见相关文献介绍;传代方法:1:4-1:10传代;每周2次。;生长特性:贴壁生长;形态特性:上皮细胞样;相关产品有:HSC-I细胞、OV-1063细胞、MiaPaCa2细胞
KYSE 70 Cells;背景说明:详见相关文献介绍;传代方法:1:2-1:3传代;每周换液2-3次。;生长特性:贴壁或悬浮,详见产品说明书部分;形态特性:详见产品说明书;相关产品有:REC细胞、Pt-K1细胞、Kit225-K6细胞
NCIH23 Cells;背景说明:详见相关文献介绍;传代方法:1:3传代;3-4天1次。;生长特性:贴壁生长;形态特性:上皮样;相关产品有:mIMCD-3细胞、SUPM2细胞、U-118-MG细胞
SU-DHL-5 Cells;背景说明:详见相关文献介绍;传代方法:1:2-1:3传代;每周换液2-3次。;生长特性:贴壁或悬浮,详见产品说明书部分;形态特性:详见产品说明书;相关产品有:WiDr-TC细胞、PC3-M细胞、MCA 38细胞
NCl-H157 Cells;背景说明:详见相关文献介绍;传代方法:1:2传代;生长特性:贴壁生长 ;形态特性:详见产品说明书;相关产品有:BC-027细胞、HITT15细胞、MDA-134细胞
RM1 Cells;背景说明:前列腺癌;C57BL/6;传代方法:1:2-1:3传代;每周换液2-3次。;生长特性:贴壁;形态特性:详见产品说明书;相关产品有:NCIH208细胞、RAMSCs细胞、CFPAC-1细胞
GM-346 Cells;背景说明:皮下结缔组织;自发永生;雄性;C3H/An;传代方法:1:2-1:3传代;每周换液2-3次。;生长特性:贴壁;形态特性:详见产品说明书;相关产品有:OVHM细胞、KM H-2细胞、NBLS细胞
Hs821T Cells;背景说明:详见相关文献介绍;传代方法:1:2传代;每周换液2-3次;生长特性:贴壁生长;形态特性:成纤维细胞;相关产品有:ATC241细胞、HCC2279细胞、MZ-CRC-1细胞
HAP1 IRF2BPL (-) 2 Cells(提供STR鉴定图谱)
HCT-8/S11 Cells(提供STR鉴定图谱)
HPS0948 Cells(提供STR鉴定图谱)
JoN LDF Cells(提供STR鉴定图谱)
MDCC-HP9 Cells(提供STR鉴定图谱)
ND41658 Cells(提供STR鉴定图谱)
PSFDFSV40T319 Cells(提供STR鉴定图谱)
SMZ-1 Cells(提供STR鉴定图谱)
Ubigene HCT 116 CSNK1G1 KO Cells(提供STR鉴定图谱)
VUB06 Cells(提供STR鉴定图谱)
4.2-05 Cells(提供STR鉴定图谱)
RC-4B Cells;背景说明:详见相关文献介绍;传代方法:1:2-1:3传代;每周换液2-3次。;生长特性:贴壁或悬浮,详见产品说明书部分;形态特性:详见产品说明书;相关产品有:RIN-14B细胞、MDA468细胞、MonoMac1细胞
H-2023 Cells;背景说明:详见相关文献介绍;传代方法:每周换液2次;生长特性:贴壁或悬浮,详见产品说明书部分;形态特性:详见产品说明书;相关产品有:Kelly细胞、NCI-H102细胞、Reh细胞
JIMT1 Cells;背景说明:乳腺癌;女性;传代方法:1:2-1:3传代;每周换液2-3次。;生长特性:贴壁;形态特性:详见产品说明书;相关产品有:SKMel-28细胞、CL40细胞、Calu-6细胞
MC3T3-E Cells;背景说明:详见相关文献介绍;传代方法:1:2-1:3传代;每周换液2-3次。;生长特性:贴壁或悬浮,详见产品说明书部分;形态特性:详见产品说明书;相关产品有:SK-RC-42细胞、LNCaP细胞、FLC7细胞
NS-1 Cells;背景说明:这是P3X63Ag8(ATCCTIB-9)的一个不分泌克隆。Kappa链合成了但不分泌。能抗0.1mM8-氮杂鸟嘌呤但不能在HAT培养基中生长。据报道它是由于缺失了3-酮类固醇还原酶活性的胆固醇营养缺陷型。检测表明肢骨发育畸形病毒(鼠痘)阴性。;传代方法:1:2传代,3天内可长满。;生长特性:悬浮生长;形态特性:淋巴母细胞;相关产品有:MADB 106细胞、MLOY4细胞、KYSE-140细胞
MT-2 Cells;背景说明:详见相关文献介绍;传代方法:1:2-1:3传代;生长特性:悬浮生长;形态特性:淋巴母细胞;相关产品有:Stanford University-Diffuse Histiocytic Lymphoma-16细胞、SKNO-1细胞、RPTEC TERT1细胞
JROECL 21 Cells;背景说明:详见相关文献介绍;传代方法:1:2传代;生长特性:贴壁生长;形态特性:上皮样;相关产品有:KATOIII细胞、MD Anderson-Metastatic Breast-231细胞、MeT5A细胞
COLO_320DM Cells;背景说明:该细胞可产生5-羟色胺、去甲、、ACTH和甲状旁腺素。角蛋白、波形蛋白弱阳性。培养条件: RPMI 1640 10%FBS;传代方法:1:2-1:3传代;每周换液2-3次。;生长特性:悬浮+贴壁;形态特性:淋巴细胞;相关产品有:HANK-1细胞、SUDHL-8细胞、H22细胞
SO-RB50 Cells;背景说明:视网膜母细胞瘤;女性;传代方法:1:2-1:3传代;每周换液2-3次。;生长特性:悬浮;形态特性:详见产品说明书;相关产品有:U118-MG细胞、NP69SV40T细胞、H-660细胞
SK-NMC Cells;背景说明:这株细胞与HTB-11都是神经源的。1971年9月分离得到SK-N-MC后,发现它有中性多巴胺-β-羟化酶活性,也有细胞内儿茶胺,用甲醛可以诱导出荧光。;传代方法:1:6-1:12传代,每周2-3次换液。;生长特性:贴壁生长;形态特性:上皮样;相关产品有:Swiss 3T6细胞、PAI细胞、MAEC细胞
HCC827 Cells;背景说明:这株细胞建于1994年三月。这株肺腺癌在EGFR酪酸激酶区域有一个获得性突变(E746-A750缺失)。患者在25岁到26岁时每个月抽1包烟。在诊断前12年不再抽烟。;传代方法:消化5分钟。1:2。4-5天长满。;生长特性:贴壁生长;形态特性:上皮细胞样;相关产品有:CAL 148细胞、CHO-S细胞、NTERA-2/D1细胞
NH6 Cells;背景说明:详见相关文献介绍;传代方法:1:2传代;每周换液2-3次;生长特性:贴壁生长;形态特性:成纤维细胞;相关产品有:MonoMac6细胞、WERI细胞、HDQ-P1细胞
U-343 Cells;背景说明:详见相关文献介绍;传代方法:1:2传代;生长特性:贴壁生长 ;形态特性:详见产品说明书;相关产品有:P3HR1-BL细胞、HCCC9810细胞、786-0细胞
RH35 Cells;背景说明:在糖皮质激素、胰岛素或cAMP衍生物的诱导下可以产生酪酸基转移酶;可被逆转录病毒感染;可产生白蛋白、转铁蛋白、凝血酶原;在AxC大鼠中可以成瘤。;传代方法:1:2传代;生长特性:贴壁生长;形态特性:上皮样;相关产品有:Hs606T细胞、SK-N-BE(2)C细胞、HCE-T细胞
Colo699 Cells;背景说明:详见相关文献介绍;传代方法:1:2-1:3传代;每周换液2-3次。;生长特性:贴壁或悬浮,详见产品说明书部分;形态特性:详见产品说明书;相关产品有:H-2330细胞、H-661细胞、HCT116/L细胞
Simpson Cells;背景说明:来源于一位61岁的男性浆细胞瘤患者;可产生免疫球蛋白轻链,未检测到重链。;传代方法:按1:2传代,5-6小时可以看到细胞分裂;生长特性:悬浮生长;形态特性:淋巴母细胞样;相关产品有:RERFLCMS细胞、TE-9细胞、UMRC-2细胞
NIH3T3-L1 Cells;背景说明:3T3-L1是从3T3细胞(Swissalbino)中经克隆分离得到的连续传代的亚系。该细胞从快速分裂到汇合和接触性抑制状态经历了前脂肪细胞到脂肪样细胞的转变。该细胞鼠痘病毒阴性;可产生甘油三酯,高浓度血清可增强细胞内脂肪堆积。;传代方法:1:2传代;生长特性:贴壁生长;形态特性:成纤维细胞样;相关产品有:KE 37细胞、Hs294细胞、HCC38细胞
NIT-1 Cells;背景说明:详见相关文献介绍;传代方法:1:2-1:3传代,每周换液1-2次;生长特性:贴壁生长;形态特性:上皮样;相关产品有:NPA 87细胞、Co-115细胞、HCC202细胞
UM-UC14 Cells;背景说明:肾癌;男性;传代方法:1:2-1:3传代;每周换液2-3次。;生长特性:贴壁;形态特性:详见产品说明书;相关产品有:NCIH510细胞、OVCAR 8细胞、Psi2-DAP细胞
UM-UC14 Cells;背景说明:肾癌;男性;传代方法:1:2-1:3传代;每周换液2-3次。;生长特性:贴壁;形态特性:详见产品说明书;相关产品有:NCIH510细胞、OVCAR 8细胞、Psi2-DAP细胞
SKO3 Cells;背景说明:SK-OV-3由G.Trempe和L.J.Old在1973年从卵巢肿瘤病人的腹水分离得到。 此细胞对肿瘤坏死因子和几种细胞毒性药物包括白喉毒素、顺铂和阿霉素均耐受。 在裸鼠中致瘤,且形成与卵巢原位癌一致的中度分化的腺癌。;传代方法:1:2-1:3传代;每周换液2-3次。;生长特性:贴壁;形态特性:上皮细胞样;相关产品有:143 B细胞、NCIH460细胞、CV-1 in Origin Simian-7细胞
NCIH446 Cells;背景说明:该细胞是1982年由CarneyD和GazdarAF等从一位小细胞肺癌患者的胸腔积液中建立的。细胞的原始形态并不具有小细胞肺癌特征。这个细胞株是小细胞肺癌的生化和形态学上的变种,表达神经元特有的烯醇酶和脑型肌酸激酶同工酶;左旋多巴脱羧酶、蚕素、抗利尿激素、催产素或胃泌激素释放肽未达到可检测水平。与正常细胞相比,该细胞c-mycDNA序列扩增约20倍,RNA增加15倍。最初传代培养基用含有5%FBS的RPMI1640,另外添加10nM化可的松、0.005mg/ml胰岛素、0.01mg/ml转铁;传代方法:1:2传代;生长特性:贴壁/悬浮生长,混合;形态特性:上皮样;相关产品有:Medical University of Graz-Chordoma 1细胞、Ketr3细胞、HRA 19细胞
Mouse podocyte Cells;背景说明:肾;足 Cells;传代方法:1:2-1:3传代;每周换液2-3次。;生长特性:贴壁;形态特性:详见产品说明书;相关产品有:PANC 813细胞、MEC-1细胞、L5178Y-R细胞
LAN6 Cells;背景说明:详见相关文献介绍;传代方法:1:2-1:3传代;每周换液2-3次。;生长特性:贴壁或悬浮,详见产品说明书部分;形态特性:详见产品说明书;相关产品有:TE-8细胞、AD-293细胞、U373细胞
MRC5 Cells;背景说明:MRC-5细胞系来自14周龄男性胎儿的正常肺组织,该细胞老化前能传代42~46个倍增时间。;传代方法:1:2-1:5传代;每周1-2次。;生长特性:贴壁生长;形态特性:成纤维细胞样;相关产品有:SKNBE-1细胞、DSL6A/C1细胞、PCI-4B细胞
AGS Cells;背景说明:TheAGS细胞株源自一个未经治疗的切除肿瘤碎块。在下述培养基中植板率为34%。支原体感染后消除。;传代方法:消化3-5分钟,1:2,3天内可长满;生长特性:贴壁生长;形态特性:上皮样;相关产品有:Glioma 261细胞、B 95.8细胞、H-596细胞
HCT-GEO Cells;背景说明:结肠癌;传代方法:1:2-1:3传代;每周换液2-3次。;生长特性:贴壁;形态特性:详见产品说明书;相关产品有:SF 126细胞、H460细胞、NALM6细胞
┈订┈购(技术服务)┈热┈线:1┈3┈6┈4┈1┈9┈3┈0┈7┈9┈1【微信同号】┈Q┈Q:3┈1┈8┈0┈8┈0┈7┈3┈2┈4;
VMCUB-1 Cells;背景说明:详见相关文献介绍;传代方法:1:2-1:3传代;每周换液2-3次。;生长特性:贴壁或悬浮,详见产品说明书部分;形态特性:详见产品说明书;相关产品有:Huh 7.5.1细胞、NB1RGB细胞、NOR10细胞
ATN1 Cells;背景说明:详见相关文献介绍;传代方法:1:2-1:3传代;每周换液2-3次。;生长特性:贴壁或悬浮,详见产品说明书部分;形态特性:详见产品说明书;相关产品有:NOR 10细胞、GM-215细胞、H-727细胞
H-125 Cells;背景说明:腺鳞状肺癌;男性;传代方法:1:2-1:3传代;每周换液2-3次。;生长特性:贴壁;形态特性:详见产品说明书;相关产品有:U937细胞、MV4II细胞、P388细胞
COS1 Cells;背景说明:该细胞源自CV-1细胞株,经转染编码野生型T抗原、起始点缺陷突变的SV40得到;细胞中整合有SV40基因组完整早期区段的单个拷贝。该细胞表达T抗原,适用于需要SV40T抗原表达的载体的转染;保留SV40溶细胞性生长的特性;支持40℃时温度敏感性A209病毒的复制;支持早期区段缺失的SV40纯体的复制。因含有SV40的DNA序列,该细胞需要在2级生物安全柜中操作。;传代方法:1:2传代;生长特性:贴壁生长;形态特性:成纤维细胞样;相关产品有:Pa14C细胞、H-1373细胞、YT细胞
K562/ADR Cells;背景说明:详见相关文献介绍;传代方法:1:2-1:3传代;每周换液2-3次。;生长特性:贴壁或悬浮,详见产品说明书部分;形态特性:详见产品说明书;相关产品有:LCMS细胞、PG-4细胞、HSC-I细胞
J774A.1 Cells:小鼠单核巨噬细胞系代次低(带STR鉴定报告)
210RCY3-Ag1.2.3 Cells;背景说明:详见相关文献介绍;传代方法:1:2-1:3传代;每周换液2-3次。;生长特性:贴壁或悬浮,详见产品说明书部分;形态特性:详见产品说明书;相关产品有:C32 [Human melanoma]细胞、QSG-7701细胞、NCIH650细胞
16HBE14o- Cells;背景说明:详见相关文献介绍;传代方法:1:2传代;生长特性:贴壁生长 ;形态特性:详见产品说明书;相关产品有:Panc 3.27细胞、16HBEo-细胞、RPMI.8226细胞
EST50 Cells;背景说明:详见相关文献介绍;传代方法:1:3-1:5传代,2-3天换液1次。;生长特性:混合生长;形态特性:成纤维细胞;相关产品有:CCD-1095Sk细胞、CHL-IU细胞、SK-N-AS细胞
NCIADRRES Cells;背景说明:详见相关文献介绍;传代方法:1:2-1:3传代;每周换液2-3次。;生长特性:贴壁或悬浮,详见产品说明书部分;形态特性:详见产品说明书;相关产品有:RWPE-1细胞、HTR-8细胞、PLC-PRF-5细胞
P30-OHKUBO Cells;背景说明:详见相关文献介绍;传代方法:10^5 cells/60mm dish;生长特性:悬浮生长;形态特性:淋巴母细胞;相关产品有:NCM460细胞、231-luc细胞、HCAEC细胞
RC-4B Cells;背景说明:详见相关文献介绍;传代方法:1:2-1:3传代;每周换液2-3次。;生长特性:贴壁或悬浮,详见产品说明书部分;形态特性:详见产品说明书;相关产品有:MESSA细胞、BV2细胞、LIXC002细胞
BayGenomics ES cell line RHA124 Cells(提供STR鉴定图谱)
BayGenomics ES cell line XD185 Cells(提供STR鉴定图谱)
CPTC-SLC31A2-3 Cells(提供STR鉴定图谱)
MEF Actbf/f-Actg1f/f Cells(提供STR鉴定图谱)
SHM-A6 Cells(提供STR鉴定图谱)
LNCaP95 clone F2 Cells(提供STR鉴定图谱)
"